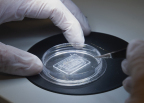

Sensera Inc. announced that it is now certified to the ISO 13485:2016 quality standard. ISO 13485:2016 specifies requirements for a quality management system, related to medical devices.
WOBURN, Mass.--(BUSINESS WIRE)-- Sensera Inc., a leading provider of MEMS devices, announced that it is now certified to the ISO 13485:2016 quality standard. ISO 13485:2016 specifies requirements for a quality management system, related to medical devices.
This press release features multimedia. View the full release here: https://www.businesswire.com/news/home/20181003005293/en/

MEMS pressure sensors - ready for attachment to fiber optics and integrated into an implantable surgical device. (Photo: Business Wire)
“We have focused on medical device component fabrication and assemblies over the last two years and this certification solidifies our support of our customers’ quality requirements. Achieving this standard recognizes our investments in our quality systems, our people and our customers,” said Tim Stucchi, General Manager/COO of Microdevices at Sensera.
“Sensera is well-positioned, due to significant experience in manufacturing components for our medical customers where a microsensor, microfluidic channel or specialized assembly is incorporated into the diagnostic or medical system,” said Ralph Schmitt, CEO at Sensera. “ISO 13485:2016 is the affirmation of processes we have built in-house supporting our growing medical segment, and it is a true reflection of our long term focus in this market.”
Sensera previously achieved ISO 9001:2015 certification in 2017, and differentiates itself as a bespoke MEMS / microfabrication provider. Sensera makes products such as pressure sensors on a wafer level that are used in vivo, but also integrates these sensors into sub-assemblies to allow its customers ‘plug and play’ integration into their life saving products.
“As a part of our commitment to our growing customer base we embarked upon the ISO path aggressively and are extremely proud to have attained certification in less than 12 months,” said Stucchi. “Sensera has been determined to build quality into our manufacturing processes since day one, and have thus been able to achieve both ISO 9001 and ISO 13485 certifications in little more than a year.”
Michael Wilkinson, Chairman & Acting CEO at MiniFAB, a manufacturer of polymer microfluidic based medical diagnostic and life science research devices said, “I’d like to congratulate Sensera on recently passing their ISO 13485 audit. Sensera’s wafer materials and processes play an important role in a number of products that we’ve developed. Their ISO 13485 accreditation will help further expand the opportunities to collaborate and innovate together in the future.”
Micro-ElectroMechanical-Systems (MEMS) is an innovative technology used to make miniaturized mechanical and electro-mechanical elements that are employed in medical devices through microfabrication techniques. According to Stratistics Market Research Consulting, the rapidly growing (18.7% CAGR) global MEMS medical device market is expected to reach $10.4B by 2022.
About Sensera Limited (ASX:SE1)
Sensera is an Internet of Things (IoT) solution provider that delivers sensor-based products transforming real-time data into meaningful information, action and value. The company designs and manufactures hardware and software across the vertical technology spectrum from unique structures as MicroElectroMechanical Systems (MEMS) and sensors, as well as wireless networked systems and software that when combined, drive an entire IoT platform solution.
Shares in Sensera Limited (ASX:SE1) are traded on the Australian Securities Exchange (ASX). For more information, please visit our website: www.sensera.com.
Any forward-looking statements in this announcement are not guarantees of future performance and involve known and unknown risks, uncertainties, assumptions and other important factors, many of which are beyond the control of the Company, its directors and management.
View source version on businesswire.com: https://www.businesswire.com/news/home/20181003005293/en/
Contacts
Sensera Inc.
Ralph Schmitt
Chief Executive Officer
+1 978 606 2600
info@sensera.com
or
Tim Dohrmann
Investor Relations
+61 468 420 846
tim@nwrcommunications.com.au
or
Press
Embedded PR
Cynthia Hoye, + 1 408-858-2602
ch@embedded-pr.com
Source: Sensera Inc.